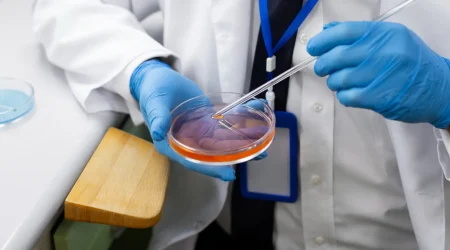
Stem-cell-and-tissue-engineering

Transform Your Future in Health Science
ABOUT ITHS
India’s Leading Institute for Next-Gen Health Science Programs
Institute of Translational Health Science (ITHS) is a leading center for advanced health science education in India. We offer globally aligned programs in Clinical Embryology, Stem Cell Technology, Cancer Biology, Nutrigenetics, and Anthropology.
Our mission is to equip students with real-world skills through hands-on lab training, research-focused learning, and UGC-approved degrees — making them career-ready health science professionals.
UGC-Recognized Degrees with Global Relevance
Hands-On Lab Training with Real Clinical Exposure
Industry Partnerships for Research & Placement
Expert Faculty & Research Mentorship

Explore Our Programs
Learning Environment & Research Facilities at ITHS
Specialized Labs Across Disciplines
On-Campus Clinical Exposure
Smart, Interactive Classrooms
AV-enabled spaces for immersive, cross-disciplinary education with interactive tools.
Research-Driven Ecosystem
WHY ITHS?
Transform Your Future In Health Science
Learn across diverse fields: Stem Cell Tech, Nutrigenetics, Cancer Biology, Embryology & Anthropology.
Gain hands-on experience with advanced labs and hospital-based training.
Work on real research projects with guidance from patented faculty and industry experts.
Build your career with strong pathways in biotech, clinical research, IVF, and global academics.

University Partner



Internship & Placement Partners








Students Experience
The Institute of Translational Health Science ART Clinical Embryology program is more than just an academic program; it's a supportive community. The faculty and staff genuinely care about their student's success, and they provide a wealth of resources to help you achieve your goals. The program also fosters a strong sense of camaraderie among students, which was a valuable part of my experience.
Honestly, I wasn't sold on Nutrigenetics at first. But after just one semester at Institute of Translational Health Science, I'm a total believer! The courses are fascinating, and the professors make complex topics clear and engaging. The best part? We get to apply what we learn in real-world settings. This semester, I'm working on a research project that could personalize nutrition plans based on individual genetics. It's truly groundbreaking. If you're looking for a program that pushes boundaries and makes a difference, choose ITHS Nutrigenetics!
Ever since I learned about the link between genes and nutrition, I knew the Institute of Translational Health Science was the place for me. The Department of Nutrigenetics here is cutting-edge. We're not just learning about food; we're exploring how it interacts with our bodies on a deeper level. The professors are leading researchers, and their passion is contagious. Plus, the program offers so many opportunities – from research labs to internships with leading food companies. If you're passionate about food, health, and the future, Institute of Translational Health Science, Nutrigenetics is the perfect program!
Coming to Institute of Translational Health Science, I wasn't sure exactly what I wanted to specialize in. But the Nutrigenetics department offers a fantastic range of courses, from personalized nutrition to the impact of food on chronic diseases. Now, I'm hooked! The professors are incredibly supportive, and the small class sizes allow for personalized attention. I recently joined a student group that explores the ethical considerations of Nutrigenetics. This program has helped me find my passion and purpose. If you're looking for a supportive environment to explore your interests in food and health, come to ITHS.
Institute of Translational Health Science, Department of Nutrigenetics isn't just about textbooks and lectures. The program offers incredible opportunities for practical experience. Through internships at local clinics and partnerships with food companies, I've gained valuable real-world skills. I also participated in a study abroad program that explored global food trends and their impact on health. This program prepares you not just for graduation but for a successful career in the ever-evolving field of Nutrigenetics.
Institute of Translational Health Science, Department of Nutrigenetics isn't just about textbooks and lectures. The program offers incredible opportunities for practical experience. Through internships at local clinics and partnerships with food companies, I've gained valuable real-world skills. I also participated in a study abroad program that explored global food trends and their impact on health. This program prepares you not just for graduation but for a successful career in the ever-evolving field of Nutrigenetics.
My experience at the Institute of Translational Health Science (ART Clinical Embryology) was nothing short of phenomenal. The department's commitment to excellence in both education and research provided me with the skills and knowledge I needed to thrive in this dynamic field. The professors were incredibly supportive and always went the extra mile to ensure my success. I highly recommend this program to anyone interested in pursuing a career in ART Clinical Embryology.
The Institute of Translational Health Science's ART Clinical Embryology program is truly one-of-a-kind. The curriculum is rigorous and comprehensive, covering all the latest advancements in the field. The program's focus on hands-on learning was invaluable, and I felt fully prepared for my career after graduation. The Institute's strong industry connections also helped me land my dream job at a leading fertility clinic.
If you're looking for a program that will challenge you and prepare you for a successful career in ART Clinical Embryology, then the Institute of Translational Health Science is the place for you. The faculty are experts in their fields, and their passion for the subject matter is truly contagious. The program's small class sizes allowed for personalized attention, and I felt like I could approach my professors with any questions or concerns.
I came to the Institute of Translational Health Science with a strong interest in ART Clinical Embryology, but I wasn't sure if I had what it takes to be successful in this field. The program's faculty and staff believed in me from the start, and their encouragement helped me to push myself beyond my comfort zone. I am so grateful for the Institute's support, which has helped me to achieve my dream of becoming a clinical embryologist.
The Institute of Translational Health Science, ART Clinical Embryology program is well-equipped with state-of-the-art technology. This allowed me to gain hands-on experience with the latest equipment and techniques used in the field. This practical experience has been invaluable in my job search and has given me a competitive edge over other applicants."
The Institute of Translational Health Science, ART Clinical Embryology program is at the forefront of the field. The curriculum is constantly evolving to reflect the latest advancements in technology and best practices. This ensures that graduates are well-prepared to enter the workforce with the most up-to-date knowledge and skills.
The Institute of Translational Health Science, ART Clinical Embryology program is a great choice for students who are interested in a career that is both intellectually stimulating and personally rewarding. Working in this field allows you to make a real difference in the lives of others, and the Institute equips you with the skills and knowledge you need to be successful.
The Institute of Translational Health Science, ART Clinical Embryology program provides students with a strong foundation in the scientific principles underlying ART procedures. However, the program also emphasizes the ethical considerations involved in this field. This well-rounded approach has prepared me to be not only a competent embryologist but also a compassionate healthcare provider.
The Institute of Translational Health Science, ART Clinical Embryology program is a great choice for students who are interested in a career that is both intellectually stimulating and personally rewarding. Working in this field allows you to make a real difference in the lives of others, and the Institute equips you with the skills and knowledge you need to be successful.
The Institute of Translational Health Science, ART Clinical Embryology program is a global program. The student body is diverse, and I had the opportunity to learn from and collaborate with classmates from all over the world. This experience has given me a valuable global perspective on the field of ART.
Are you passionate about translating scientific discoveries into real-world treatments? The Department of Stem Cell & Regenerative Medicine at the Institute of Translational Health Science offers a unique opportunity to contribute to the future of medicine. Our rigorous program equips you with the knowledge and skills to bridge the gap between lab and clinic. Join us and make a difference in the lives of millions.
The Department of Stem Cell & Regenerative Medicine at Institute of Translational Health Science has opened doors I never knew existed. The courses are challenging but incredibly rewarding, and the professors are leading experts who are passionate about the field. The research opportunities are phenomenal, allowing me to gain hands-on experience in a cutting-edge lab. Being at ITHS feels like being at the forefront of medical discovery. It's the perfect place for anyone who wants to be a physician-scientist and make a real difference in healthcare.
I chose Institute of Translational Health Science, Stem Cell & Regenerative Medicine program because I want to be at the forefront of patient care. The program delves into the ethical considerations and potential applications of these therapies. It's clear that the faculty prioritizes patient well-being and responsible research. This program has equipped me with the knowledge and skills to be a strong advocate for patients as these therapies move toward clinical practice.
The Department of Stem Cell & Regenerative Medicine at Institute of Translational Health Science is a haven for interdisciplinary thinkers. The program combines biology, engineering, and medicine, which perfectly matches my interests. The curriculum is diverse, and there are opportunities to collaborate with students from other departments. Being at ITHS has been a truly enriching experience that has broadened my perspective on the field.
Life At ITHS












Blog
Assisted Reproductive Technology Course in India: Complete Guide 2026
Complete guide to ART courses in India 2026. BSc, MSc, Diploma programs, fees ₹2-6L, top…
Food Nutrition and Dietetics: Complete Career Guide – Courses, Jobs & Salary
Explore Food Nutrition and Dietetics: courses, jobs, salary in India & abroad. Build a rewarding…
India’s 1st B.Tech in Stem Cell & Tissue Engineering – Join ITHS at Rayat Bahra University
Enroll in India's 1st B.Tech in Stem Cell & Tissue Engineering at ITHS. Build a…
FREQUENTLY ASKED QUESTIONS
FAQs About Training Programs
All programs include hands-on training in specialized labs, covering real-time procedures like stem cell processing, embryology, molecular diagnostics, and more.
Yes, practical sessions and industry-based exposure are integrated into the curriculum. Some advanced modules may have additional training fees, which are clearly mentioned during admission.
All workshops, certificate programs, and lab-based training include official certificates issued by ITHS in collaboration with Rayat Bahra University.
Absolutely. ITHS welcomes students from across India, Nepal, Africa, and the Middle East. Online counseling and visa support are available for international applicants.